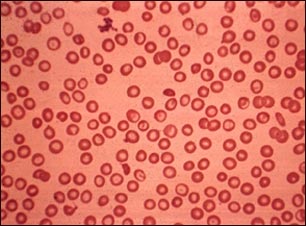
Talasemia menor

![]() | ![]() | ![]() |
Talasemia menor
La talasanemia menor es un tipo hereditario de anemia hemolítica menos severo que la talasanemia mayor. Este frotis de sangre perteneciente a un individuo que padece talasanemia muestra glóbulos rojos sanguíneos de varias formas (poiquilocitosis), pálidos (hipocrómicos) y pequeños (microcíticos), los cuales tienen menor capacidad para transportar el oxígeno que los glóbulos rojos sanguíneos normales.
Actualizado: 5/3/2006
